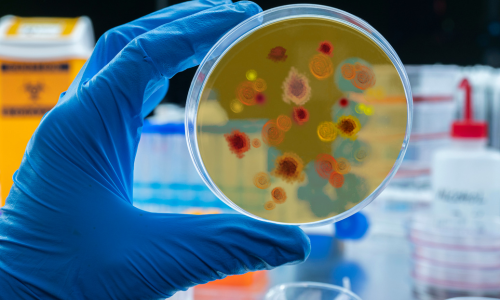

Medical Consultation in Modern Era In healtheare, effective communication is the cornerstone of quality patient care. "Medical Consultation in Modern Era" goes beyond conventional medical guides by offering a holistic approach to improving consultation practices. This book integrates the art and science of communication, making it an essential resource for healtheare professionals. Why This Book Stands Out "Medical Consultation in Modern Era" bridges the gap between clinical expertise and patient interaction. Written by seasoned experts, it combines theoretical knowledge with practical insights, ensuring readers can apply concepts in real-world scenarios.

Dr. Subhash Kumar
Dr.Subhash Kumar is a renowned Diabetes, thyroid, and obesity Specialist practicing in Patna, Bihar, India. He is the Director of the Diabetes and Obesity Care Center located at the center of the city. He is also a medical consultant to India Oil Corporation, Bihargrid Corporation, and CIMP and Teaching faculty in the university of South Wales UK.
Our Services


Our Departments

Biochemistry

Clinical Laboratory

Electronic Data processing
Epidemiology

Medical Records

Primary Prevention of Diabetes

Social Education

Prevention of Diabetes Kidney Disease
Nourish Your Body: Take Charge of Your Wellness Journey with Our Complimentary Weekly Dietary Assessment!



Full Blood sugar Test

Cardiac check up

Foot care and education

Diabetes education

Kidney checkup

Obesity checkup

Excellent

.png)
Mr. Prashant Raj Gupta
2024-01-18
.png)
Manish Kumar
2023-12-15
.png)
Anjali Vijaya
2024-05-04
.png)
WARIS PHYSICS CLASSES
2024-04-18

Sanjay Kumar
2024-04-18

mukesh kumar pandit
2023-12-11

Nirmit Kumari
2024-04-18
.png)
Jitendra Singh
2024-04-18
If You Have Any Query, Please Contact Us














































.jpeg)

.jpeg)